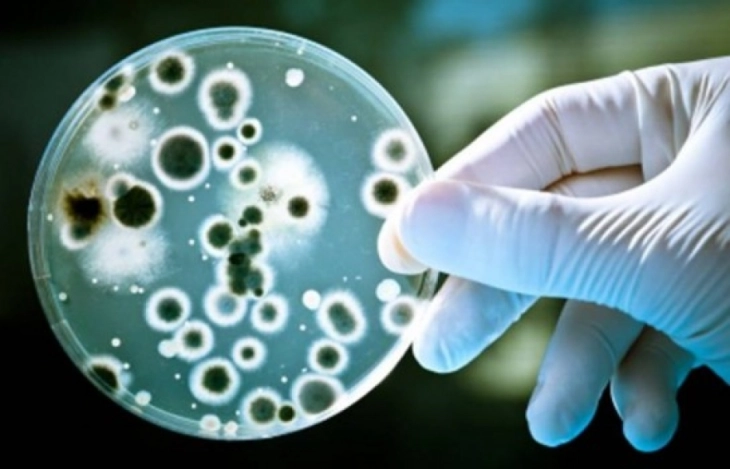
Zbulohet gjurma më e hershme deri më tani e bakterit të murtajës, e vjetër 5.500 vjet

Zbulohet gjurma më e hershme deri më tani e bakterit të murtajës, e vjetër 5.500 vjet
- Një studim i shkencëtarëve nga universitetet në Kembrixh dhe Kopenhagen ka zbuluar provën më të vjetër të ADN-së të murtajës - patogjenin bakterial "Yersinia pestis", në mbetje njerëzore të vjetra rreth 5.500 vjet. Në punimin shkencor të botuar në revistën "Nejçër"(Nature) janë analizuar mostrat e ADN-së nga kockat dhe dhëmbët e 1.313 njerëzve që jetuan në Evropë dhe Azi gjatë Epokës së Gurit (37.000 - 12.500 vjet më parë), deri në 200 vjet më parë.
Kopenhagen, 10 korrik 2025 (MIA) - Një studim i shkencëtarëve nga universitetet në Kembrixh dhe Kopenhagen ka zbuluar provën më të vjetër të ADN-së të murtajës - patogjenin bakterial "Yersinia pestis", në mbetje njerëzore të vjetra rreth 5.500 vjet. Në punimin shkencor të botuar në revistën "Nejçër"(Nature) janë analizuar mostrat e ADN-së nga kockat dhe dhëmbët e 1.313 njerëzve që jetuan në Evropë dhe Azi gjatë Epokës së Gurit (37.000 - 12.500 vjet më parë), deri në 200 vjet më parë.
Shkencëtarët kanë identifikuar 214 patogjenë që kanë sulmuar njerëzit në të kaluarën, duke përfshirë sëmundjet zoonotike - ato të transmetuara nga kafshët te njerëzit - ndërsa janë të vjetra të paktën 6.500 vjet. Profesori Eske Villerslev deklaroi se kalimi nga jeta e vështirë kur mereshin me gjah drejt jetës me bujqësi dhe blegtori ka hapur një ekopë të re të sëmundjeve ngjitëse.
“Këto infeksione nuk shkaktuan vetëm sëmundje, por mund të kenë çuar edhe në rënien e popullsisë, migrimin dhe përshtatjen gjenetike”, thotë ai.
Janë zbuluar edhe gjurma të difterisë (të vjetra 11.000 vjet), hepatitit B (9.800 vjet) dhe malaries (nga 4.200 vjet më parë). ls/
Foto: Arkivi i MIA-s







